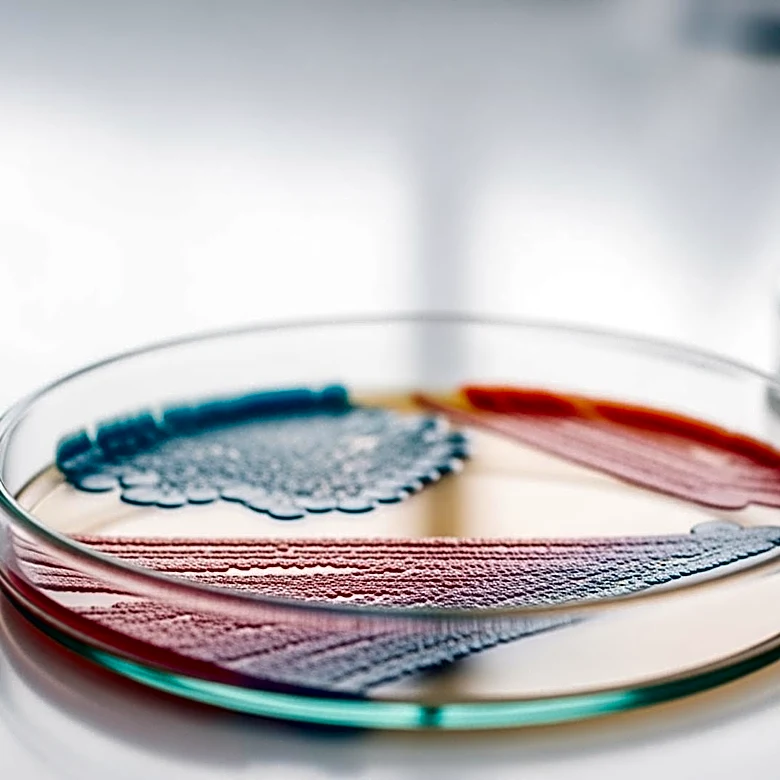
Gut Microbiome Changes Linked to Parkinson's Disease Risk

El aceite vegetal es un ingrediente esencial en la cocina, utilizado para freír, aderezar ensaladas y preparar salsas. Su versatilidad y variedad lo convierten en un elemento indispensable en la gastronomía mundial. Sin embargo, su uso no solo se limita a la cocina, ya que también tiene implicaciones en la salud y nutrición.
Variedades de aceite vegetal
El aceite vegetal puede ser de origen vegetal o, más raramente, animal. Entre los aceites vegetales más comunes se encuentran el de oliva, palma, soja, colza, maíz y girasol. Cada uno de estos aceites tiene características únicas que los hacen adecuados para diferentes tipos de cocina. Por ejemplo, el aceite de oliva es conocido por su sabor distintivo y es ideal para aderezar ensaladas y preparar salsas como el alioli y la mayonesa.
Además, el aceite vegetal puede ser aromatizado sumergiendo hierbas frescas, pimienta, ajo y otros condimentos. Sin embargo, es importante tener cuidado al almacenar aceites aromatizados para evitar el crecimiento de bacterias como el Clostridium botulinum, que produce toxinas peligrosas.
Salud y nutrición
El consumo de aceite vegetal tiene implicaciones importantes para la salud. La cantidad adecuada de grasa en la dieta diaria es objeto de debate. Mientras que la FDA recomienda que un máximo del 30% de las calorías diarias provengan de grasas, otros expertos sugieren que no más del 10% de la ingesta calórica diaria debería ser grasa.
Las grasas saturadas, aunque necesarias en pequeñas cantidades, han sido asociadas con enfermedades cardiovasculares. Sin embargo, estudios recientes han mostrado que cambiar el consumo de carbohidratos por grasas saturadas puede tener efectos positivos o neutrales. Los aceites con menores cantidades de grasas saturadas, como el de oliva y colza, son considerados más saludables.
Impacto en la salud cardiovascular
El aceite vegetal puede influir en los niveles de colesterol. Los aceites ricos en grasas insaturadas, como el de soja y girasol, pueden ayudar a reducir el colesterol LDL, conocido como el colesterol "malo", y aumentar el HDL, el colesterol "bueno". Sin embargo, estos efectos aún están siendo estudiados.
Es importante destacar que no todas las grasas saturadas tienen efectos negativos sobre el colesterol. Por ejemplo, el ácido palmítico del aceite de palma se comporta de manera neutral respecto a los niveles de colesterol. Además, el consumo de aceite de palma ha demostrado reducir el colesterol en comparación con otras fuentes de grasas saturadas.
En conclusión, el aceite vegetal es un componente versátil y esencial en la cocina, con importantes implicaciones para la salud. Su uso adecuado puede contribuir a una dieta equilibrada y saludable.